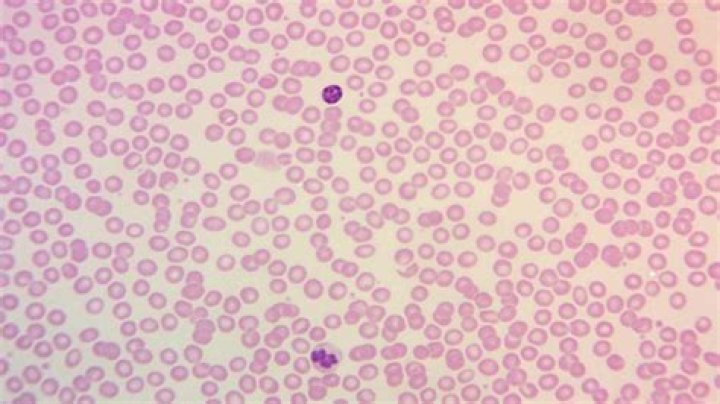

What is the purpose of using Leishman’s stain?
Leishman stain contain methylene blue dye, a basic dye, which gives colour to an acidic component and eosin dye, an acidic dye, which gives colour to a basic component. These dyes differentiate the different component of blood.
What is the purpose of using Leishman’s stain?
Leishman stain, also known as Leishman’s stain, is used in microscopy for staining blood smears. It is generally used to differentiate between and identify white blood cells, malaria parasites, and trypanosomas.
What is the difference between Giemsa and Leishman stain?
The key difference between Giemsa Stain and Leishman Stain is that Giemsa staining is useful in the staining of DNA regions of different chromosomes to investigate different aberrations such as translocations and rearrangements, while Leishman stain is useful during blood smear staining and analysis to differentiate
What is the fixative present in Leishman stain?
The fixative present in Leishman stain is Buffered formalin J10% formalin ~Ethy alcohol ~Acetone free methanol 02. All of the following are Romanowsky stains EXCEPT ~Leishman stain Glemsa staln ~Hematoxylin stain ~Field staln Q.
Why Leishman stain is used in blood smear?
Leishman stain is used in microscopy for staining blood smears. It provides excellent stain quality. It is generally used to differentiate and identify leucocytes, malaria parasites, and trypanosoma. It is based on a methanolic mixture of “polychromed” methylene blue.
What is the purpose of methyl alcohol in Leishman’s stain?
Leishman’s stain contains eosin and methylene blue in acetone free methyl alcohol. Methyl alcohol acts as a fixative. (acetone if present, will destroy the cell membrane).
What stain is used for malaria?
The Giemsa stain is used as the gold standard for the diagnosis of malaria on blood smears. The classical staining procedure requires between 30 and 45 min.
Is Leishman stain a romanowsky stain?
Stains that are related to or derived from the Romanowsky-type stains include Giemsa, Jenner, Wright, Field, May鈥揋r眉nwald and Leishman stains.
Which stain is used in DLC?
Such stains are called as ‘Romanowsky stain’. The three different types of Romanowsky stains are commonly in use.
Which stain is used for reticulocyte count?
The most common supravital stain is performed on reticulocytes using new methylene blue or brilliant cresyl blue, which makes it possible to see the reticulofilamentous pattern of ribosomes characteristically precipitated in these live immature red blood cells by the supravital stains.
How do you remove a Leishman stain?
In the present study, detailed experiments are carried out to remove Leishman stain by adsorption technique using natural, local clay as low cost adsorbent 鈥淨ulapalk clay鈥.
What is smear study?
A blood smear is a blood test used to look for abnormalities in blood cells. The three main blood cells that the test focuses on are: red cells, which carry oxygen throughout your body. white cells, which help your body fight infections and other inflammatory diseases.
How do you stain Leishman?
2) Cover the film with Leishman’s Stain (S018S) and allow to act for 1 minute. Methanol in the stain fixes the preparation. 3) Add double the volume of distilled water to the slide and mix. 4) Allow the diluted stain to act for 10-12 minutes.
Why is methyl alcohol free in water?
It should be water-free because water if present will lead to rouleaux formation, hemolysis and precipitation of the stain components.
Why Giemsa stain is used?
Giemsa stain is used in Giemsa banding, commonly called G-banding, to stain chromosomes and often used to create a karyogram (chromosome map). It can identify chromosomal aberrations such as translocations and rearrangements.
Why do we fix thin blood smear?
A thin blood smear is a drop of blood that is spread across a large area of the slide. Thin blood smears helps doctors discover what species of malaria is causing the infection.



